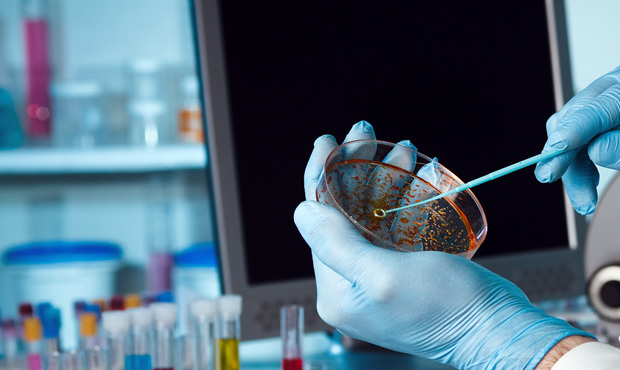

Customers trust us consistent high quality product, to a certain extent, depends on our carefully chosen for raw materials and suppliers, and each procedure strictly control the production process. Of course, it is important that all of our raw materials through rigorous testing and control, to ensure the excellent quality, safety and traceability. We can track every batch of products of raw materials and process conditions.
We use two kinds of process to produce gelatin: alkaline or acid method. Each stage of production process are under strict hygiene conditions, and will not happen in the whole manufacturing process of chemical modification. Formed at the end of the process, gelatin gel strip, then we are going to the drying and crushing into granule, then granular gelatin stored, according to different customers and applications for further processing.